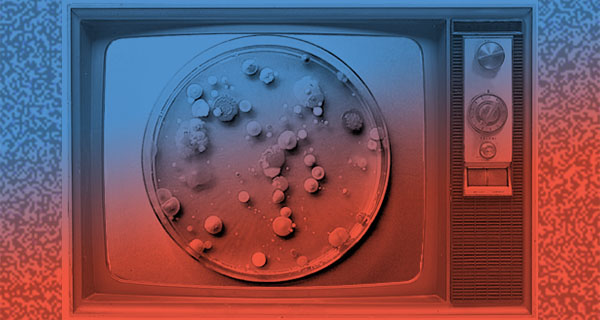

Boundaries: The Ninth Annual Northwestern Bioethics and Medical Humanities Conference
Monday, April 13, 2026
Overview
The Center for Bioethics and Medical Humanities and the Medical Humanities & Bioethics Graduate Program are excited to announce this one-day conference dedicated to engaging the Northwestern and Chicagoland community in the rich, multidisciplinary research and scholarship of our field.
Keynote
To Suffer What We Can’t Evade: What Is Medicine’s Role in Responding to Suffering?
![]() |
Tyler Tate, MD, MA Associate Professor of Pediatrics, Stanford University School of Medicine, and Core Faculty, Stanford Center for Biomedical Ethics (SCBE) |
In medicine, suffering matters: encountering suffering and helping patients cope with, and navigate through suffering, are key functions of healthcare. In addition, the concept of suffering plays an important role in many high-stake areas of medical ethics including medical aid-in-dying and/or euthanasia, moral distress/burnout, and policies addressing “futility,” or medically-ineffective treatment. Yet for all its gravity and salience, the concept of suffering is underdetermined. In this talk, I will briefly survey the history of the concept of suffering in American biomedicine. Then, I will discuss my own research on suffering and offer a novel theory of suffering for medicine and bioethics: The Gap Theory of Suffering, where suffering is defined as the experience of a gap between how things are and how things ought to be. Finally, I will examine the implications of the Gap Theory and offer recommendations on how clinicians and bioethicists can both respond to suffering ethically and accompany patients well along the road of suffering and illness.
Other Programming
Additionally, four panels of presenters—including clinicians, graduate students, medical students, and researchers—will explore the theme and other topics within bioethics and medical humanities.
Session 1: Ethical Boundaries
- Disciplinary Boundaries and Responsibility in Transplant Care | Cassandra B. Iroz, MS
- Fit Enough to Live? Physical Fitness, Frailty, and the Ethical Boundaries of Transplant Eligibility in Liver Care | Martha Castellini
- Seeing Through Technical and Ethical Boundaries: The Future of AI-Powered Smart Glasses for Health & Well-being Self-Management | Tim Schwirtlich, MS
- Pushing the Scalpel’s Edge: Regulatory and Ethical Boundaries for Artificial Intelligence in Surgery | Nivedita Kumar and John Fornagiel
Session 2: Spatial Boundaries
- The Goldwater Rule: Is It Time to Redraw the Boundaries? | David Kendall Casey, MA
- Ethical Decision Making at the Geographical Margin: Spatial Spillovers and
the Responsibilities of Health Systems to One Another | Jaida B. Pryor, MS, LMFT-A and Jake Mackie, MS - How the Political Boundaries of State Borders Affect the Provision of Reproductive Medical Care | Rebecca Feinberg, JD, MBE, MS
- I Don’t Care Where You Are From. The Boundarylessness of Ancestry | Sofia Marrufo-Gonzalez, MS, MA
Session 3: Entanglement and Redefining Boundaries
- Reconsidering Boundaries in Genomic Risk Communication: An Ethical Justification for System-Led Contact Cascade Screening in the United States | Katherine Bonini, MS, MA, CGC
- Who Does What Now? How sIRB Review Reshapes Oversight, Responsibility, and Communication | Monica Kane, MPH
- Breaking Boundaries: Research History and Ethics through Graphic Narrative | Sydney Halpern, PhD
- Making Sense of Health, Trust, and Expertise: Mothers and the Rise of the MAHA Movement | Haylie June
Session 4: Liminality and Boundaries
- Redrawing the Boundaries between Safety and Risk: Incorporating Perspectives from the Disability Community | Jacqueline Kish, PhD, OTR/L and Amy McArthur, PhD, OTR/L
- The Porous Boundary: Redefining Death and Dignity in the Technological Age | Craig M. Klugman, PhD
- When Silence Harms: Reconsidering the Boundaries of CPR, Autonomy, and Informed Consent | Julie L. Campbell, JD, LLM, CHC
- Caregiving in Counterpoint | Ursula Francis, JD, PhD, MSc
Registration is open and is free to all.
If you are not local or are interested in attending just one session, we invite you to attend via Zoom instead:
Conference Theme: Boundaries
Boundaries are often created to mark the edge or extent of an area, to define where one thing stops and another begins, to mark the limits of things like places, disciplines, personal space, or behaviors. Boundaries are often negotiable. The field of bioethics has grown in part because people, technologies, and healthcare systems tend to push boundaries and sometimes redefine them. Both bioethics and medical humanities turn to multiple disciplines (like anthropology, literature, history, law) to explore where boundaries are, where they ought to be, and how they could or should be changed.
Which existing boundaries in healthcare ought to be reconsidered and which reinforced? How do new technologies or medical innovations raise ethical questions that may prompt the need to reevaluate boundaries? What is the effect of resisting or ignoring existing boundaries? What can clinicians, researchers, ethicists, patients, and communities do to ensure that boundaries, and the multiple territories they attempt to demarcate, contribute to the betterment of health and wellness? What are our responsibilities to maintain or break them?
Schedule
8:45–9:00: Check-in and light breakfast
9:00–9:15: Opening remarks
9:15–10:15: Session 1
10:15–10:30: Short break
10:30–11:30: Session 2
11:30–12:00: Break to get lunch
12:00–1:00: Lunchtime keynote
1:00–1:30: Long break
1:30–2:30: Session 3
2:30–2:45: Short break
2:45–3:45: Session 4
3:45–4:00: Closing remarks
4:00–5:00: Networking and snacks
Venue
Baldwin Auditorium in the Lurie Research Building (not to be confused with the nearby Lurie Children’s Hospital). 303 E Superior St, Chicago, IL